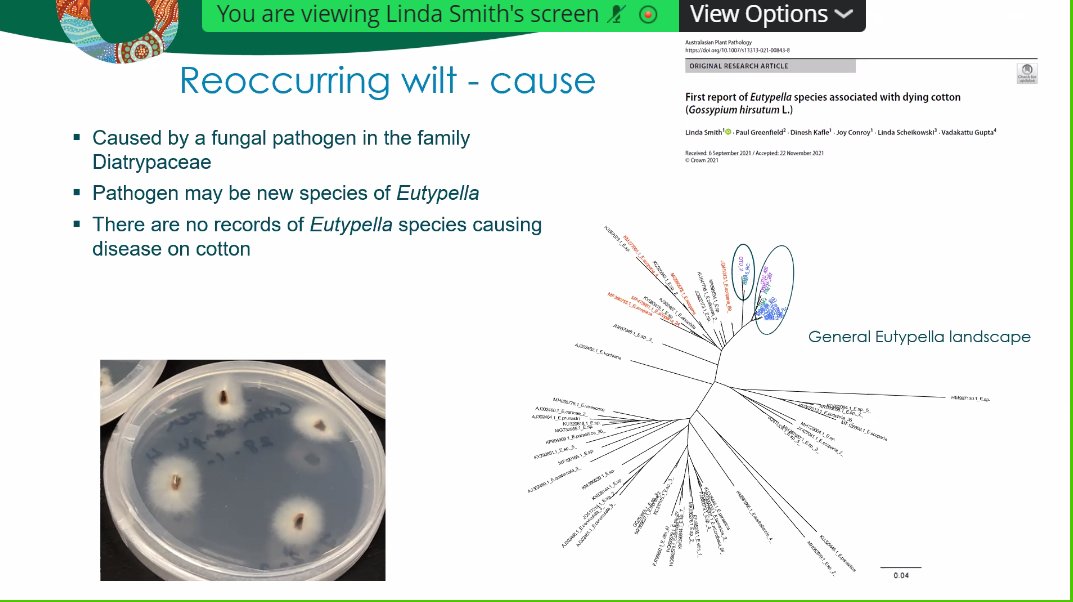
Australasian Plant Pathology Society QLD tweet media

Dr Linda Smith presents a new disease of cotton, Recurring Wilt, and an overview of other important pest & disease threats impacting the cotton industry. (PS Linda, we love that travelling around Australia is part of being a plant pathologist!) @DAFQld @CottonResearch

English



















